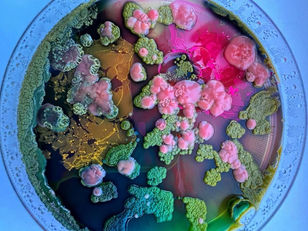
Does Humanity’s Fate Lie in the Hands of the Fungal Kingdom?

top of page

Search


Mycorena's Mycoprotein: The Future of Sustainable Eating
In the ever-evolving landscape of sustainable food innovation, a Swedish start-up by the name of Mycorena has emerged as a formidable...
Oct 19, 2023


MushLume: Biofabricated Lighting Made in NYC
Biofabricated lighting that is not manufactured but grown, MushLume Lighting Collection designs and recreates lampshades using a...
Oct 15, 2023


Myconeos: The Future of Blue Cheese is Here
Could it be the future of blue cheese? Applied to Penicillium roqueforti, the fungi responsible for gorgonzola, roquefort, stilton and...
Oct 10, 2023


The Bioartistry of Vera Meer and the Secrets of Fungal Life
Once upon a time, in the ethereal intersection of science and art, scholars roamed a landscape where creativity and curiosity coexisted...
Oct 8, 2023


Sculpting with Fungi: Jessica Dias' Hyper Articulated Mycopmorph
In the realm of innovative design, Jessica Dias presents the Hyper Articulated Mycopmorph, a remarkable table prototype. Crafted using...
Oct 4, 2023


Mycoforestry: Can Fungi Hold the Key to Sustainable Forests?
What precisely defines Mycoforestry? Picture it as permaculture for the woods, a potentially transformative answer to the environmentally...
Sep 28, 2023


Meeting Indonesian bio-inspired artist Syaiful Aulia Garibaldi
We had the pleasure of meeting Syaiful Aulia Garibaldi, bio-inspired artist, in his Bandung workshop in Indonesia 🇮🇩. Syaiful, fondly...
Sep 26, 2023


MycoTemple: a space for physical and spiritual transformation.
MycoTemple is a space for physical and spiritual transformation. It’s a five meters wide dome, woven by mycelium. This architecture...
Sep 22, 2023

Does Humanity’s Fate Lie in the Hands of the Fungal Kingdom?
We believe that fungi have silently conducted the symphony of life’s evolution on earth for the past billion years. Starting with a...
Sep 22, 2023


Fungi Food Revolution: BosqueFoods Redefines Meat with Mycelium
In the bustling realm of biotechnology, a remarkable venture named BosqueFoods emerges as a beacon of innovation. This enterprising...
Sep 18, 2023
bottom of page
